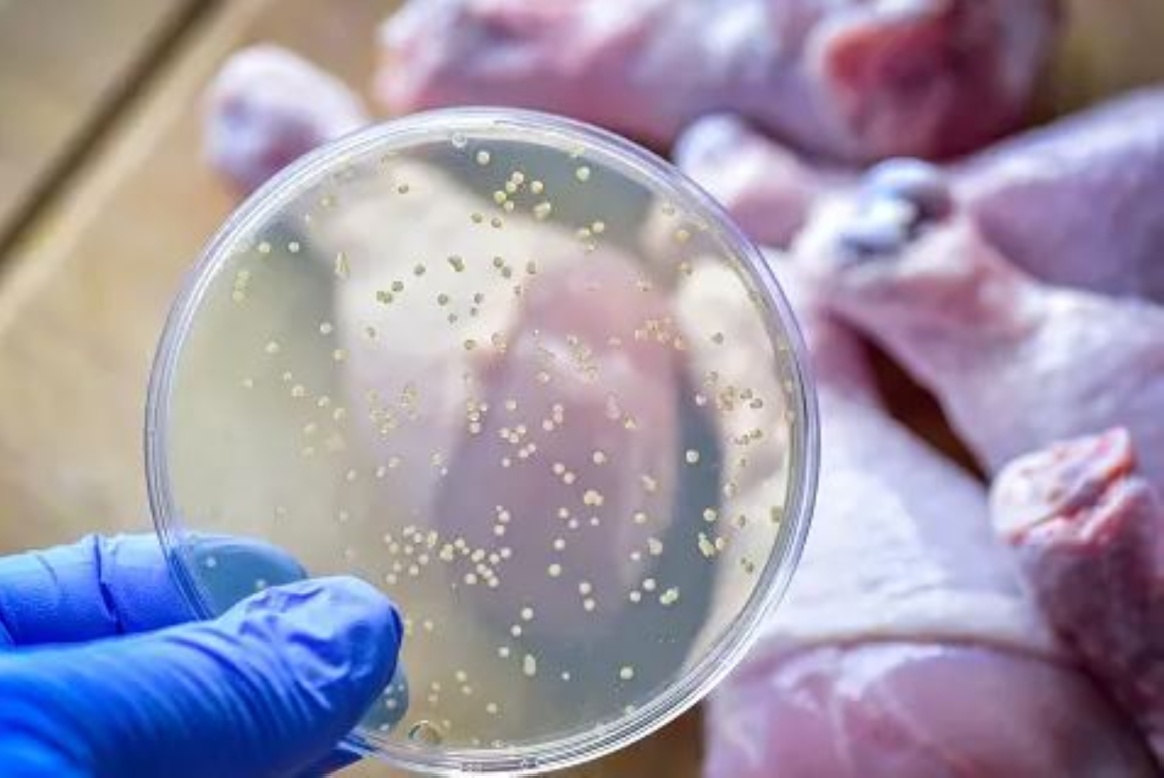

كيف نحمي أنفسنا من السالمونيلا؟
النقابي الجنوبي/متابعة خاصة
يمكن تعريف السالمونيلا، بأنها كائن حي دقيق، لا يمكن رؤيته أو شمه، ويُعثر عليها في العديد من الأماكن المختلفة بما في ذلك الأطعمة الحيوانية النيئة، وإذا تناولت هذه الأطعمة، فإنه يمكن أن يسبب الأمراض المنقولة بالغذاء، ولكن يمكن أيضًا أن ينتقل من إنسان إلى إنسان ومن حيوان إلى إنسان.
من الممكن أن تصاب بالسالمونيلا ولا تظهر عليك الأعراض وتلوث يديك وطعامك
وبحسب صحيفة “سي إن إن” بنسختها الإنجليزية، فإنه من الممكن أن تصاب بالسالمونيلا ولا تظهر عليك الأعراض، ومن ثم يمكنك تلويث يديك وطعامك، وينبغي أن تعرف أيضًا أنه ليست كل الحيوانات التي لديها السالمونيلا لديها أعراض أيضا.
وتابعت الصحيفة أنه في الولايات المتحدة، يصاب 1.35 مليون شخص كل عام بداء السالمونيلا ، فيما يدخل حوالي 26.5 ألف شخص في الولايات المتحدة إلى المستشفى، وتكون البكتيريا مسؤولة عن حوالي 420 حالة وفاة سنويًا.
هذه الأرقام هي تقديرات تفسر حقيقة أنه إذا أُصيب 30 شخصًا بالسالمونيلا، فيمكن لشخص واحد فقط أن يذهب إلى الطبيب ويقدم عينة من البراز ويحصل على النتيجة التي يتم بعد ذلك إبلاغها إلى المراكز (الأمريكية) لمكافحة الأمراض والوقاية منها.
هل بعض الأشخاص أكثر عرضة للإصابة؟
إذا كنت تتناول مضادات الحموضة، فأنت أكثر عرضة للإصابة بالأمراض المنقولة بالغذاء، ومن بينها السالمونيلا، كما أن تناول المضادات الحيوية يزيد من خطر الإصابة بالعدوى، كذلك فإن أي شخص يعاني من ضعف في جهاز المناعة، بما في ذلك كبار السن والأطفال الصغار والنساء الحوامل، يكون أكثر عرضة للخطر. إن تناول الأدوية المثبطة للمناعة يعرضك أيضًا لخطر أكبر.
كيف أحمي نفسي من السالمونيلا؟
تُوصي إدارة الغذاء والدواء على وجه التحديد بما يلي: شطف الفواكه والخضروات الطازجة تحت ماء الصنبور الجاري، بما في ذلك تلك ذات القشور، وعليك أن تنظف المنتجات الصلبة باستخدام فرشاة منتجات نظيفة.
هل يجب أن تشعر بالقلق عند تناول الطعام في المطاعم أو خارج المنزل؟
لا تطلب البرجر متوسط الطهي؛ وإذا نظرت إلى الدجاج ووجدته غير مطبوخ جيداً، قم بإعادته. وبالنسبة للحم البقر المفروم، إذا كانت السالمونيلا موجودة، فستكون موجودة على السطح الخارجي للحوم، ولكن بمجرد طحنها، يصبح الجزء الخارجي هو الجزء الداخلي.
هل السوشي آمِن؟
يُعَدّ السوشي محفوفًا بالمخاطر مثل لحم البقر النيء المفروم. حتى لو كان لديك طاهٍ حائز على نجمة ميشلان، لا ننصحك بتناوله. في الواقع، قد يكون الخطر من طاهٍ مشهور أعلى؛ لأن الطاهي قد يطحن اللحم بنفسه ويقدمه لك، في حين يتم اختبار اللحم المفروم من متجر البيع بالتجزئة وفقًا لمعايير وزارات الزراعة حول العالم.
وننصحك بألا تأكل السمك النيء، إذا كنت تتناول مضادات الحموضة أو المضادات الحيوية أو كنت تعاني من ضعف المناعة. ويجب على الأطفال الصغار والنساء الحوامل وكبار السن أيضًا تجنب الأسماك النيئة.
أفضل الطرق لتجنب الإصابة بالسالمونيلا
للحد من فرص الإصابة بالسالمونيلا، قم بطهي اللحوم والدواجن النيئة بشكل صحيح. وهذا يعني أن الحد الأدنى لدرجة الحرارة الداخلية هو 145 درجة فهرنهايت للحوم البقر ولحم الضأن ولحم العجل؛ فيما تقدر بـ160 فهرنهايت للحوم المفرومة؛ و 165 فهرنهايت لأي دواجن.
عندما يتعلق الأمر بتخزين اللحوم النيئة في الثلاجة، ضعها في أدنى نقطة ممكنة أو اتخذ احتياطات أخرى حتى لا تتساقط العصارة على الأطعمة الأخرى. يمكن أن يساعد تغليفه أو تخزينه في كيس في منع التقطير.
لا تغسل اللحوم والدواجن النيئة قبل الطهي، لأنه يمكن للبكتيريا أن تتناثر وتنتشر على الأسطح ويمكن أن تلوث الطاولات والسكاكين وألواح التقطيع. ومع ذلك، يجب عليك غسل الفواكه والخضروات أو تقشيرها قبل تناولها أو تقطيعها. ومن الحكمة أيضًا تجنب استخدام نفس الأدوات مع المنتجات النيئة والمطبوخة.
أيضًا اغسل يديك قبل التعامل مع الطعام وبعد كل مرة تلمس فيها اللحوم النيئة. نظّف جميع الأسطح بالماء الدافئ والصابون، بما في ذلك الحوض، بعد التعامل مع اللحوم النيئة. ثم قم بالتعقيم للتأكد من قتل جميع البكتيريا . يمكنك استخدام الإسفنجة في الميكروويف أو تمريرها في غسالة الأطباق.
عند التسوق، لا تفترض أن الأطعمة العضوية أو المحلية أكثر أمانًا من الأطعمة غير العضوية، حتى لو كنت تعرف اسم الدجاجة – أو حتى اسم المزارع – فهذا لا يعني أنها لا تحتوي على السالمونيلا.
وأخيرا لا تُقبِّل حيواناتك الأليفة، اغسل يديك بعد لمس الحيوانات وكن حذرًا بشكل خاص مع الزواحف، بما في ذلك السلاحف والإغوانا والثعابين.